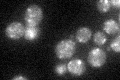
YLR039C
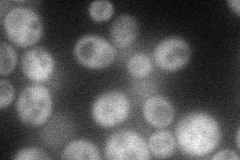
YLR039C
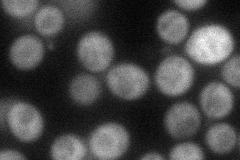
YLR039C
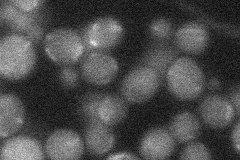
YLR039C
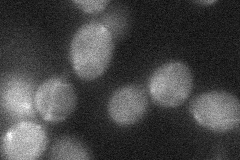
YLR039C
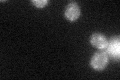
YLR039C

View description
Protein involved in retrograde transport to the cis-Golgi network; forms heterodimer with Rgp1p that acts as a GTP exchange factor for Ypt6p; involved in transcription of rRNA and ribosomal protein genes
Localization:
Intensity:
Fold change:
Significance:
-
C’ GFP library in SD
punctate26.2 -
N' NOP1pr-GFP in SD
cytosol47.2443 -
N' TEF2pr-mCherry in SD
cytosol50.4246 -
N' NATIVEpr-GFP in SD
below threshold19.7436 -
N' TEF2pr-VC and Cyto-VN in SD
below threshold26.4925 -
C’ GFP library in SD+DTT
punctate26.931.02No -
C’ GFP library in SD+H2O2

punctate29.11.11No -
C’ GFP library in Starvation Media

punctate30.21.15No -
C’ GFP library on the background of Pup2-DaMP

punctate -
C’ GFP library on the background of CCT mutant

punctate29.26621.11669No
